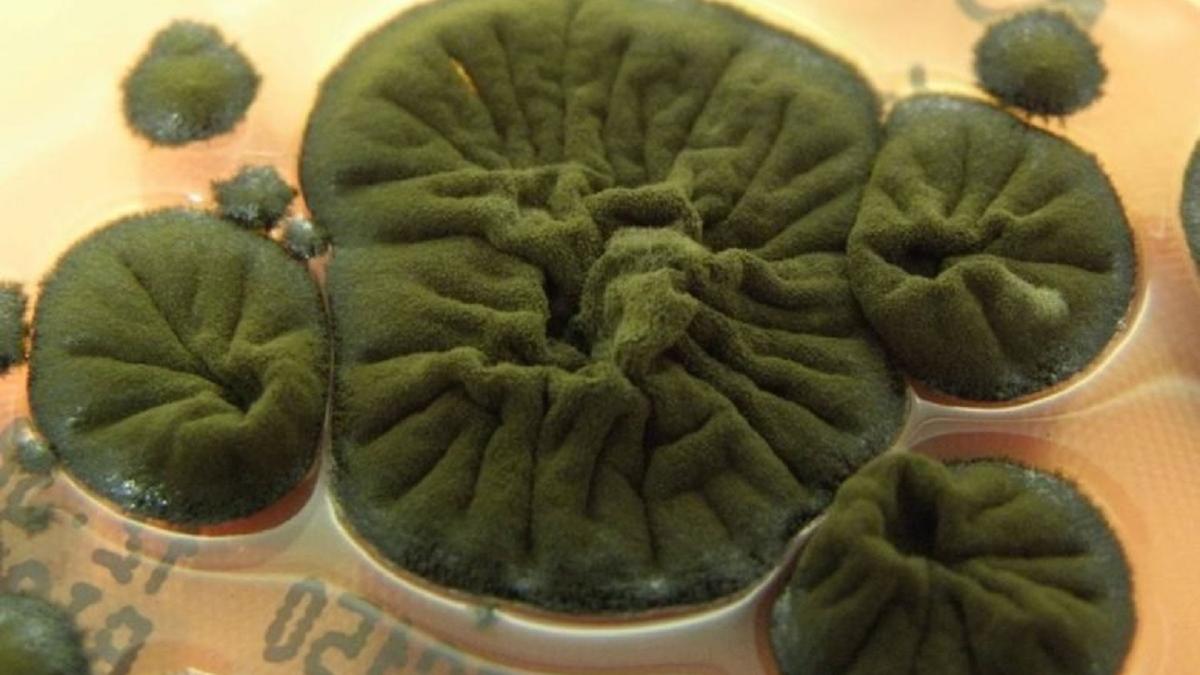

Поглощающий радиацию гриб из Чернобыля ставит ученых в тупик
new-science.ru
Почти четыре десятилетия после катастрофы на Чернобыльской АЭС в самых радиоактивных руинах реактора процветает уникальная форма жизни — черный грибок Cladosporium sphaerospermum. Он не просто выживает под воздействием ионизирующего излучения, но демонстрирует в нём ускоренный рост. Этот феномен бросает вызов фундаментальным представлениям о пределах жизни и возможных механизмах её адаптации.
Ключ к разгадке учёные видят в меланине — тёмном пигменте, который в изобилии содержится в клетках гриба. В 2008 году была выдвинута революционная гипотеза «радиосинтеза». Согласно ей, меланин может действовать подобно хлорофиллу у растений, но вместо солнечного света использовать ионизирующее излучение, преобразуя его энергию для метаболизма гриба. Этот механизм теоретически мог бы одновременно и питать, и защищать организм.
Однако спустя годы прямых и неоспоримых доказательств «радиосинтеза» так и не получено. Исследователям не удалось зафиксировать, чтобы излучение напрямую приводило к фиксации углерода или давало грибку те метаболические преимущества, которые однозначно подтвердили бы новую форму хемосинтеза.
Интрига вокруг чернобыльского гриба вышла за пределы Земли. В 2022 году эксперимент на Международной космической станции показал, что Cladosporium sphaerospermum способен эффективно поглощать и блокировать космическое излучение. Это открывает практические перспективы для создания на его основе лёгких биологических защитных экранов для длительных космических миссий.
Таким образом, скромный черный грибок из зоны отчуждения продолжает оставаться одной из увлекательных научных загадок, пишет new-science.ru. Его способность не просто сопротивляться, но, возможно, и «питаться» смертоносным излучением, ставит перед наукой фундаментальные вопросы и служит ярким примером невероятной изобретательности жизни, которая находит способы процветать там, где это, казалось бы, невозможно.
